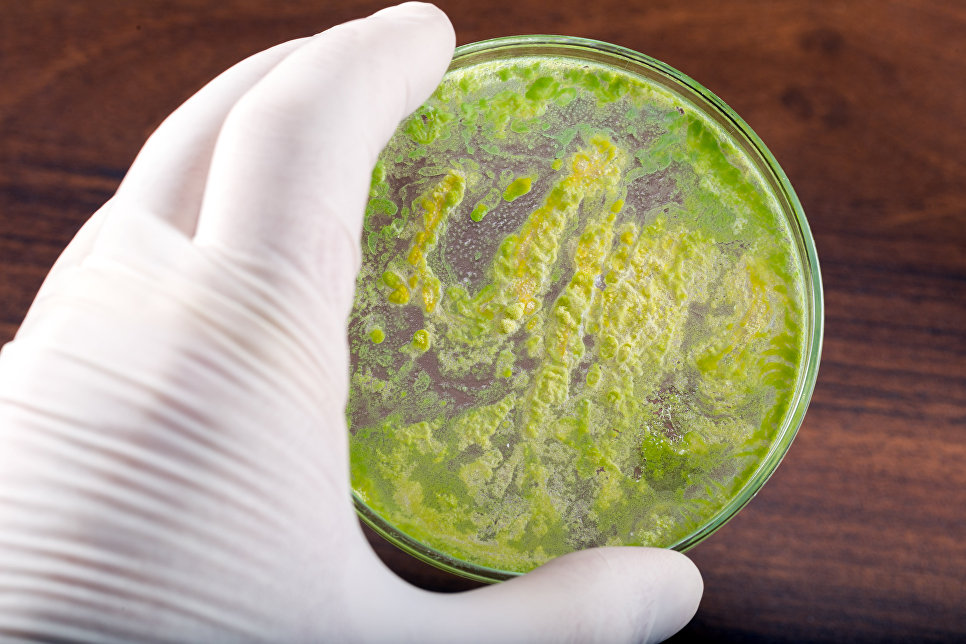

"Белок ОСР и его "кузены" являются уникальными модульными конструкциями, способными выполнять различные функции в клетке – от переноса гидрофобных молекул аниоксидантов и до превращения энергии квантов света в тепло. К примеру, мы уже выяснили, как можно определять температуру на уровне микро- и наноразмерных объектов при помощи этого белка", — рассказывает Евгений Максимов, биофизик из МГУ, чьи слова приводит пресс-служба вуза.
За миллионы лет эволюции растения и цианобактерии научились захватывать фотоны солнечного света и использовать их энергию для сборки молекул питательных веществ. С одной стороны, этот процесс очень эффективен с точки зрения химии, а с другой — растения используют лишь 1-2% от общей энергии излучения Солнца. Учитывая нарастающий продовольственный кризис и нужду в "зеленых" источниках топлива, ученые в последние годы неоднократно пытались "улучшить" КПД растений.
Одним из главных ограничителей в эффективности фотосинтеза являются сами растения или микробы – когда они считают, что свет Солнца является чрезмерно ярким, их листья и клетки начинают рассеивать свет, превращая его в тепло, тем самым защищая себя от ожогов и чрезмерно сильного испарения воды.
Когда жара спадает, они возвращаются в нормальное состояние далеко не сразу, что заметно понижает эффективность фотосинтеза. В целом, как показывают расчеты ученых, этот "безопасный режим" снижает максимальную эффективность растений, растущих в средней полосе США или России, на 25-30%.
Как отмечает Максимов, ученые достаточно давно пытаются "взломать" эту систему защиты от перегрева и поменять ее работу таким образом, чтобы растение одновременно не убивало себя, и чтобы его урожайность стала намного более высокой. Некоторые успехи уже были достигнуты в этом направлении – год назад генетики из США создали ГМО-табак, растущий на четверть быстрее обычного.
Российские генетики и их коллеги из Германии попытались осуществить аналогичные изменения в клетках цианобактерий, набирающих биомассу значительно быстрее, чем растения, и считающихся сегодня одними из главных кандидатов на роль "колонизаторов" Марса и источников пищи и кислорода для путешествий в дальний космос.
Клетки этих микробов содержат в себе два белка, управляющих скоростью фотосинтеза – OCP и FRP. Первый играет роль "тормоза" – он поглощает частицы света и меняет свою структуру, мешая молекулам хлорофилла и другим компонентам фотосинтезирующих систем взаимодействовать со светом. Когда уровень освещения падает, молекулы OCP постепенно возвращаются в исходное состояние и скорость фотосинтеза начинает расти.
В свою очередь, FRP играет роль своеобразной газовой педали – он взаимодействует с молекулами OCP и ускоряет их переход в исходное состояние. Как это происходит и что именно меняет FRP, ученые не знали до настоящего времени.
Максимов и его коллеги проследили за взаимодействиями "активированной" формы OCP и различных версий FRP, выделенных из клеток нескольких видов цианобактерий, нагревая их до высоких или низких температур и подсвечивая их большими или малыми порциями света.
Выяснив, как именно соединяются эти белки, ученые создали несколько мутантных версий FRP, "запретив" его молекулам распадаться на половины, не способные нормально прикрепляться и взаимодействовать с OCP. Подобные версии FRP, по словам Максимова и его коллег, значительно ускорили работу фотосинтетических систем микроба и заставили их быстрее расти.
Дальнейшая оптимизация структуры FRP не только повысит скорость набора биомассы, но и позволит использовать фотосинтезирующих микробов и их белки для множества других целей, в том числе наблюдений за различными процессами внутри клеток человека и других млекопитающих.

